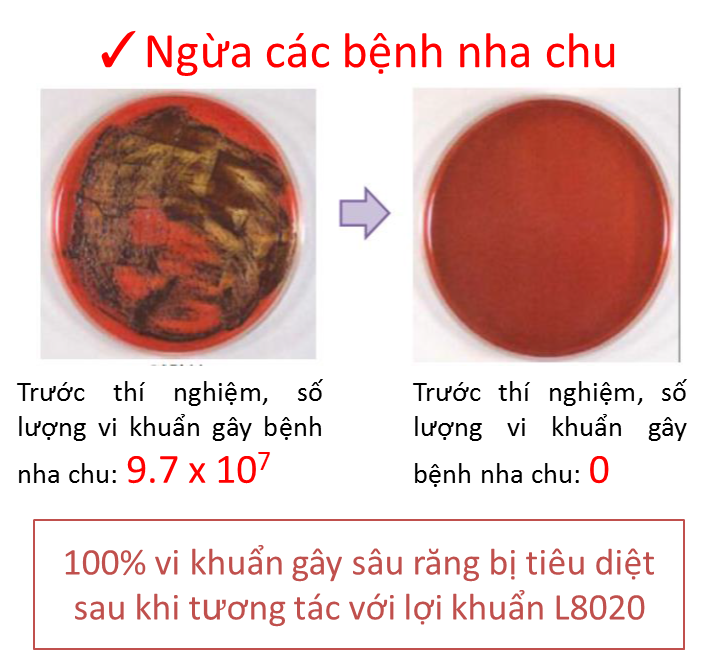

Sức Khoẻ
Mách mẹ 4 bí quyết chăm sóc răng như người Nhật

Mách mẹ 4 bí quyết chăm sóc răng như người Nhật
Đừng chờ đến khi trẻ mọc đầy đủ răng hay thậm chí tới tận khi bị sâu mới bắt đầu chú ý tới răng miệng. Với người Nhật, các bà mẹ đã chú trọng tới điều này ngay từ khi trẻ còn bú mẹ. Đó là lý do vì sao mà tất cả các trẻ em Nhật đều sở hữu những chiếc răng trắng và khỏe mạnh. Mẹ hãy học ngay 4 bí quyết chăm sóc răng dưới đây của những bà mẹ Nhật nhé!

Làm sạch răng miệng cho trẻ sau mỗi cữ bú
1. Vệ sinh miệng sau mỗi cữ bú
Không chỉ thực hiện với các bé bú bình, những bé bú mẹ cũng không quên được làm sạch khoang miệng thường xuyên bằng các dụng cụ rơ lưỡi chuyên dụng. Đặc biệt thói quen bú đêm của bé thường vô tình khiến tình trạng sâu răng trở nên trầm trọng hơn. Vì vậy, mẹ hãy chú ý vệ sinh răng miệng thường xuyên cho bé ít nhất mỗi ngày một lần nhé!
2. Chải răng ngay khi có chiếc răng đầu tiên
Các em bé Nhật đều được làm quen với bàn chải từ rất sớm. Những chiếc bàn chài dành cho bé thường có mặt chải nhỏ (chỉ vừa đủ rộng để chải 1-2 chiếc răng của trẻ), mềm và đặc biệt có những hình thù, màu sắc rất bắt mắt.
Thời gian đầu trẻ mới chỉ biết gặm và chơi đùa với bàn chải như một đồ chơi thông thường nhưng sau đó, bé sẽ quen dần với việc chăm sóc răng giống như người lớn.

Trẻ em Nhật được mẹ hỗ trợ đánh răng tới tận 8-9 tuổi
3. Học đánh răng tại nhà và tại trường
Trẻ không chỉ được học cách chăm sóc răng miệng ở nhà mà còn được hướng dẫn chải răng tại trường thông qua những bài học trực quan và cả những bài hát ngộ nghĩnh, thú vị.
Đặc biệt, sau khi tự chải răng, trẻ vẫn sẽ được người thân hỗ trợ đánh răng tới tận khi 8-9 tuổi. Điều này được xem như một hoạt động gắn kết gia đình và giúp đảm bảo làm sạch răng một cách tốt nhất.
4. Bảo vệ răng nhờ lợi khuẩn L8020
Ngoài các phương pháp vệ sinh răng miệng, các bà mẹ tại Nhật còn giúp trẻ bảo vệ răng lợi bằng lợi khuẩn L8020. Đây là một loại vi khuẩn hữu ích, được Hiệp hội Nha sĩ các trường học Nhật Bản khuyến cáo. L8020 có tác dụng tăng cường vi khuẩn tốt, giảm vi khuẩn gây hại, cải thiện môi trường khoang miệng.
Thí nghiệm chứng minh công dụng của L8020
Các nghiên cứu cũng chỉ ra, lợi khuẩn L8020 có khả năng tiêu diệt 99.9% vi khuẩn sâu răng và 100% vi khuẩn gây nha chu. Nó còn giúp cân bằng môi trường miệng từ axit thành trung tính, giúp hàm răng được hoàn toàn khỏe mạnh.
Ý nghĩa của cái tên L8020 là “80 tuổi vẫn còn hơn 20 chiếc răng nguyên vẹn”. Đó cũng là lý do vì sao các sản phẩm chứa lợi khuẩn L8020 rất được các mẹ ưa chuộng tại Nhật Bản. Để chăm sóc và bảo vệ hàm răng khỏe mạnh, mẹ cũng hãy sử dụng viên ngậm ngừa sâu răng L8020 cho bé yêu của mình nhé!
Xem thông tin sản phẩm tại:
- Viên Ngậm Lợi Khuẩn L8020 Vị Sữa Chua
- Viên Ngậm Lợi Khuẩn L8020 Vị Chanh








